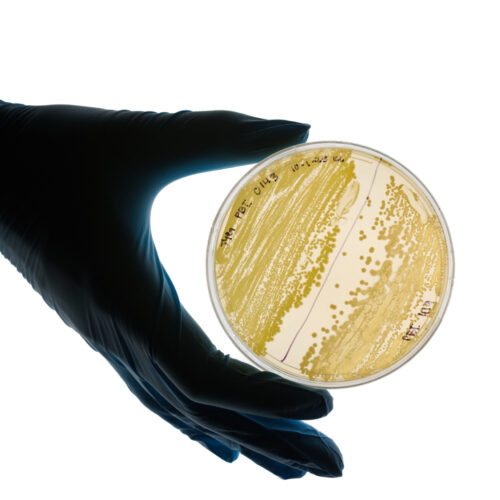
A hand wearing a blue latex glove holds a petri dish growing bacteria

The “Jungle Jumpstart” float rolls down Colorado Boulevard in Pasadena on January 1. Photo by Tom Zasadzinski.
Cal Poly universities’ 2026 rainforest-themed float won the Sweepstakes Award at the 137th Rose Parade® on New Year’s Day.
The prestigious trophy — a first in the schools’ nearly eight decades in the parade — honors the most beautiful float overall and is typically won by larger, commercially-built floats or major organizations, not by self-built entries that include the California State University campuses.
— Jay Thompson
Cal Poly is the best overall master’s-level university in the West for both public and private institutions for the third consecutive year in the U.S. News & World Report’s 2026 Best Colleges guidebook.
This is the 33rd straight year Cal Poly is ranked best public institution in the West and the third year running it has been ranked No. 1 among all 97 public and private institutions in the region, which includes California and 14 other western states.
After a two-year closure, the refreshed Robert E. Kennedy Library — the largest library between Santa Barbara and Santa Cruz — has reopened its doors and assumed its rightful spot as a hub of campus life. The space, which marked its 45th anniversary in January, reopened in September 2025. The $78-million renovation improved accessibility, added classroom space, upgraded heating and cooling systems and expanded the on-site café — all while saving energy.
“These changes give our students a more welcoming, flexible and inspiring environment to study, collaborate and create,” said Interim Dean of Library Services Katherine O’Clair. “The renovated library is a place where the entire campus community can come together to learn, connect and thrive.”
Check out a few of the library’s new additions:
START WITH ART
At the main entrance, visitors are greeted by a vibrant work of art. The acrylic mural, titled “Grounds for Growth,” is the creation of artists Joshua Lawyer and MJ Lindo-Lawyer, known as Rough Edge Collective.
FIRST FLOOR UPGRADES
The reimagined first floor holds two exhibit spaces for art and historical artifacts from Special Collections and Archives, the expanded Julian’s Café and a redesigned courtyard. The university’s 24-hour study space now includes the first and second floors.
QUESTIONS AND ANSWERS
Students also have access to the Digital Scholarship Studio, which includes a research help desk, a place to consult with peers on data science projects, group study space and computer workstations.
In late June, a payload built by Cal Poly students took a historic ride on Dawn Aerospace’s Aurora spaceplane. The flight from Tāwhaki National Aerospace Centre near Christchurch, New Zealand, carried the company’s first U.S. student-built experiment to an altitude of 37,000 feet and speeds of Mach 0.79. Students designed the payload to test whether an off-the-shelf data acquisition system could withstand the rigors of high-altitude, spaceflight-like environments with similar performance to a custom system.
Photo courtesy of Dawn Aerospace
Architecture student Leah Wilhelms sands a piece of furniture in the College of Architecture and Environmental Design’s Support Shop.
In early November, students from the College of Architecture and Environmental Design flexed their fabrication skills during the record-setting 22nd annual Vellum Furniture Competition. The largest in university history, this year’s competition featured a jaw-dropping 262 entries, including tables, chairs, light fixtures, toys and other experimental design solutions.
Fifth-year architecture student and first-time Vellum participant Grace Schweigert won the Space Architects’ Milano Grand Prize — the competition’s highest honor — for her accent chair and complementary leg rest, titled “Rembrace: Comfort in a Capitalist Context.” The set includes bean bags stuffed with hand-sewn recycled t-shirts, pants, skirts and blankets dressed in a crocheted cover — a statement on the harm she says is inherent in consumer culture.
“We know harm is happening and keep it out of view,” Schweigert said. “If we cannot see the landfill, the workers or the harm, we will carry on and overlook our impact, even when we notice it.”
— Evan Seed
During harvest this fall, Cal Poly students, faculty and staff processed millions of grapes for wine and research purposes. Here’s a look at those numbers:
tons of grapes processed for commercial wine production between September and October
estimated tons of grapes processed for research purposes between October and November
cases of wine the JUSTIN and J. LOHR Wine and Viticulture Center can hold
A research team is studying ancient bacteria in hopes that it could unlock promising new antibiotics. Led by biochemistry professor Katharine Watts and Rachel Johnson, a Frost teacher-scholar postdoctoral fellow, the group is looking at a library of ancient microbial strains that are approximately 25 to 40 million years old. The team hopes the work will provide insights into potential benefits for modern medicine.
“These bacteria samples have lived during a time we can only know through carbon dating,” said Safiya Rufino, a food science and microbiology double major who participated in the project as a BEACoN research scholar. “It makes me wonder how it would be to one day be revived millions of years in the future, how would I react? Would I still be able to function as I once did as these bacteria are able to?”
— Nick Wilson
With one of the most internationally diverse rosters in Division I, the men’s basketball team is finding strength in their differences as it rallies around a common goal.
Generations of alumni entrepreneurs returned to celebrate 20 years of Cal Poly’s Innovation Quest — a critical launchpad for budding ventures.
